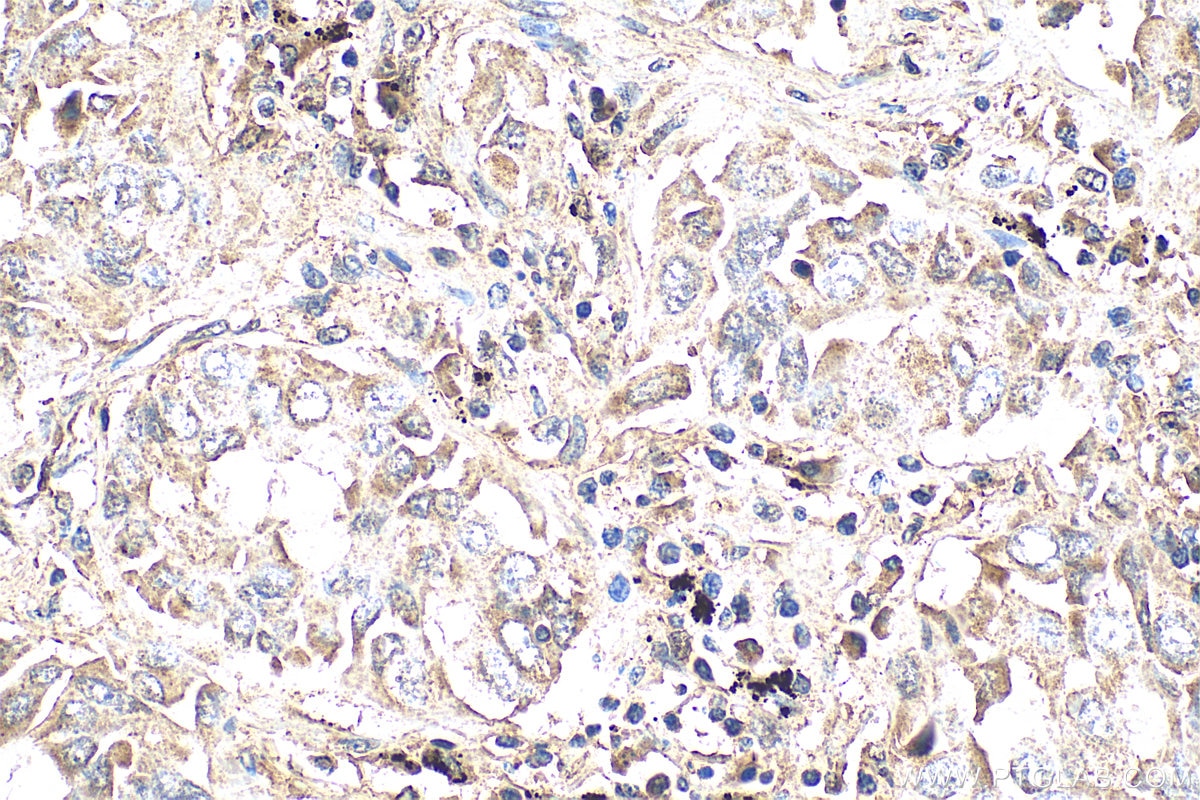
Immunohistochemistry (IHC) staining of human lung cancer tissue using WNT5A/B Polyclonal antibody (29793-1-AP)

Tested Applications
| Positive WB detected in | HUVEC cells, HeLa cells, MCF-7 cells, SKOV-3 cells |
| Positive IHC detected in | human lung cancer tissue Note: suggested antigen retrieval with TE buffer pH 9.0; (*) Alternatively, antigen retrieval may be performed with citrate buffer pH 6.0 |
| Positive IF/ICC detected in | HeLa cells |
Recommended dilution
| Application | Dilution |
|---|---|
| Western Blot (WB) | WB : 1:500-1:1000 |
| Immunohistochemistry (IHC) | IHC : 1:50-1:500 |
| Immunofluorescence (IF)/ICC | IF/ICC : 1:50-1:500 |
| It is recommended that this reagent should be titrated in each testing system to obtain optimal results. | |
| Sample-dependent, Check data in validation data gallery. | |
Published Applications
| WB | See 4 publications below |
| IHC | See 1 publications below |
| IF | See 1 publications below |
Product Information
29793-1-AP targets WNT5A/B in WB, IHC, IF/ICC, ELISA applications and shows reactivity with human samples.
| Tested Reactivity | human |
| Cited Reactivity | human, rat |
| Host / Isotype | Rabbit / IgG |
| Class | Polyclonal |
| Type | Antibody |
| Immunogen |
CatNo: Ag31507 Product name: Recombinant human WNT5A protein Source: e coli.-derived, PGEX-4T Tag: GST Domain: 330-380 aa of BC064694 Sequence: EGMDGCELMCCGRGYDQFKTVQTERCHCKFHWCCYVKCKKCTEIVDQFVCK Predict reactive species |
| Full Name | wingless-type MMTV integration site family, member 5A |
| Calculated Molecular Weight | 42 kDa |
| Observed Molecular Weight | 42 kDa |
| GenBank Accession Number | BC064694 |
| Gene Symbol | WNT5A |
| Gene ID (NCBI) | 7474 |
| RRID | AB_3086163 |
| Conjugate | Unconjugated |
| Form | Liquid |
| Purification Method | Antigen affinity purification |
| UNIPROT ID | P41221 |
| Storage Buffer | PBS with 0.02% sodium azide and 50% glycerol, pH 7.3. |
| Storage Conditions | Store at -20°C. Stable for one year after shipment. Aliquoting is unnecessary for -20oC storage. 20ul sizes contain 0.1% BSA. |
Background Information
The WNT gene family consists of structurally related genes which encode secreted signaling proteins. There are 19 Wnt genes in the human genome that encode functionally distinct Wnt proteins. These proteins have been implicated in oncogenesis and in several developmental processes, including regulation of cell fate and patterning during embryogenesis. Wnt members bind to the Frizzled family of seven-pass transmembrane proteins and activate several signaling pathway. Wnt5A is a member of the Wnt family of proteins, which are 38-45 kDa secreted cysteine-rich proteins with hydrophobic signal peptides.
Protocols
| Product Specific Protocols | |
|---|---|
| IF protocol for WNT5A/B antibody 29793-1-AP | Download protocol |
| IHC protocol for WNT5A/B antibody 29793-1-AP | Download protocol |
| WB protocol for WNT5A/B antibody 29793-1-AP | Download protocol |
| Standard Protocols | |
|---|---|
| Click here to view our Standard Protocols |
Publications
| Species | Application | Title |
|---|---|---|
J Biol Chem Exosomal miR-23a-3p derived from human umbilical cord mesenchymal stem cells promotes remyelination in central nervous system demyelinating diseases by targeting Tbr1/Wnt pathway | ||
J Orthop Res Increased Wnt5a/ROR2 signaling is associated with chondrogenesis in meniscal degeneration | ||
J Immunother Cancer Inhibition of stromal MAOA leading activation of WNT5A enhance prostate cancer immunotherapy by involving the transition of cancer-associated fibroblasts | ||
Noncoding RNA Res LncRNA NEAT1-206 regulates autophagy of human umbilical cord mesenchymal stem cells through the WNT5A/Ca2+ signaling pathway under senescence stress | ||
Biochim Biophys Acta Mol Cell Res Wnt/β-catenin signaling inhibits oxidative stress-induced ferroptosis to improve interstitial cystitis/bladder pain syndrome by reducing NF-κB |
Reviews
The reviews below have been submitted by verified Proteintech customers who received an incentive for providing their feedback.
FH Udesh (Verified Customer) (12-22-2023) | Worked well for WB at 1:2000 in ADSCs
|